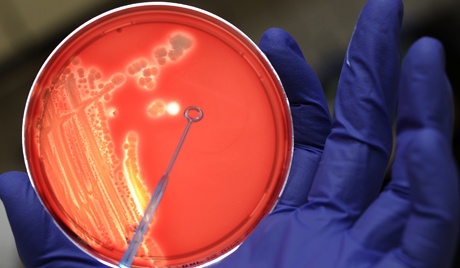

Беспокойная кафедра
все гуглят: “Вот та-ам,” “Ох!”
Скандал такой – нашли они
там фотографию - бактерии.
Бегут к завкафедрой, вопят:
“Вы это видели? Вот это ряд!”
Завкафедрою посмотрел,
понять так сразу не сумел.
“А в чем скандал? Не понял я,
обыкновенная - бактерия,
а что с бактерией не так
и кто здесь удивил всех вас?”
На шум проректор приходил,
сердито что-то говорил,
а попадал ли кто впросак,
никто не хвастался никак.
И ещё ректор позвонил,
о чём-то тоже говорил,
о чем бывал тот разговор
нам неизвестно до сих пор.
Завкафедрою посмотрел:
"А кто бывал здесь не у дел?
Заняться что ли нечем?
Сейчас занятие найду…”
Пока бумаги он искал,
исчезли все… И был финал:
бактерия хорошей стала
и срочно благодать настала.
А выводы с истории такой
возможно сделать нужно эти:
скандала нет прикольнее на свете:
“Бактерии бывают в интернете!”
Фотография из интернета.
Свидетельство о публикации №113033001300